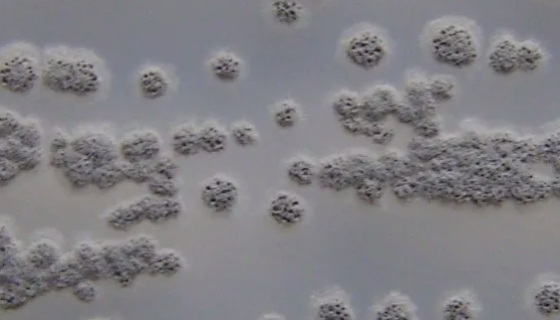
阿氟曼链霉菌的培养条件与操作方法及注意事项！

耐酸乳杆菌的培养条件与注意事项及保存方法!
耐酸乳杆菌是Lactobacillus属的微生物,原产地为中...

SCC-4人舌鳞癌细胞的处理方法及培养操作规程!
人舌鳞癌细胞源自属于I级鳞癌(T2N1Amo,Ⅱ期)的原位舌...

HMC-1人肥大细胞的培养条件与操作步骤!
人肥大细胞的培养条件与处理方法及操作步骤。

HCC515 人肺腺癌细胞的处理方法与培养步骤!
人肺腺癌细胞收到后的处理方法与培养步骤及注意事项有哪些?
阿氟曼链霉菌的培养条件与操作方法及注意事项!
阿氟曼链霉菌的打管说明及培养条件与注意事项有哪些?

ATCC 35241 柯氏动弯曲菌 百欧博伟生物
柯氏动弯曲菌,真菌界下一属,革兰氏染色可变或阴性,但细胞壁属...

脆弱拟杆菌的性质与用途及生产工艺!
脆弱拟杆菌隶属于拟杆菌门,拟杆菌科,拟杆菌属。它的最初描述是...

HCEC人角膜上皮细胞的主要功能及验收注意事项!
人角膜上皮细胞分离自眼角膜组织;角膜系眼球外膜呈半球形向前突...

蜂窝鹅绒菌的特点与功效及培养与保存方法!
蜂窝鹅绒菌,子实体多数白色,有时带粉色、黄色,较少近杏黄或带...